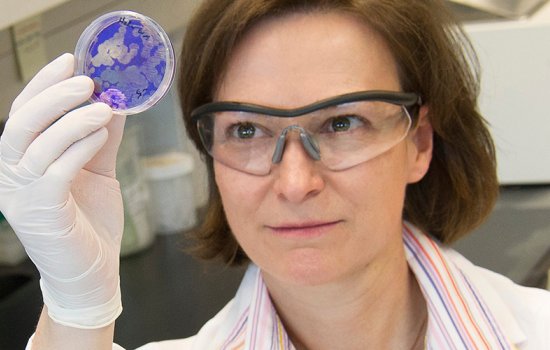
A woman scientist in lab coat looks closely at a purple culture sample encased in a round plastic disc

Leadership series to host a conversation with New York’s senate majority leader
Andrea Stewart-Cousins will the first guest of this semester's Leading Questions series.

Clear your Saturday for the Albany Book Festival
The 4th annual Albany Book Festival will be held Saturday, Sept. 25, in the Campus Center, with local authors and international best sellers, writers panel discussions, workshops, readings and a local authors marketplace.

University at Albany Honored for Commitment to Diversity
For the fourth consecutive year, UAlbany has been awarded the Higher Education Excellence in Diversity (HEED) Award from INSIGHT Into Diversity magazine, the oldest and largest diversity-focused publication in higher education.

NYS Writers Institute Announces Fall 2021 Schedule of Events
The NYS Writers Institute opens its season Thursday and has a full slate of events, most of them in-person for the first since author visits shut down in March 2020 due to the COVID-19 pandemic.

5 Questions with Mya Darsan
Junior biology and environmental science student Mya Darsan is dedicating her summer to protecting the endangered piping plovers, a species important in maintaining biodiversity in an ecosystem.

Jahnavi Bonagiri: Bridging the Digital Divide
Computer Science student Jahnavi Bonagiri is interning with the Community Impact Team at the United Way, where she is exploring ways to combat the digital divide among communities in need.
$1 Million NSF Grant will Boost Gender Equity among STEM Faculty
The University has received a prestigious $1 million, three-year grant from the NSF to create an academic and research climate where women faculty in STEM fields can thrive and develop their careers to the fullest potential.

Bank of America grant funds college prep program in STEM fields
STEP program gives Capital Region high school students a feel for college and jobs in the sciences.